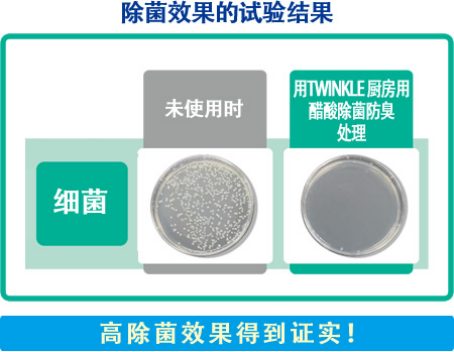

俗话说病从口入,想要身体健康,就要从入口的食物注意,而入口的食物都是从厨房端出,首先就要做好厨房的卫生。厨房被视为居家卫生清洁的重灾区,应该没有一点的夸张成分。想到曾经出租房中蟑螂爬过灶台上的惊心动魄时刻,不住泛起一阵恶心。

厨房这个区域充满了各种油烟、食物残渣,油烟机灶台、水池下水道、垃圾桶等等这些都不是蘸水就能清理干净的东西。如果只用普通的清洁方式去清理这些污渍,不仅清理不干净还引来果蝇、蟑螂这些害虫,厨房卫生堪忧,食物怎么会不沾染细菌,吃进嘴里怎么能不生病?还好有日本KINCHO金鸟推出的居家好物——KINCHO金鸟TWINKLE厨房用醋酸除菌防臭洗涤剂。
大家都知道来自日本的KINCHO金鸟是一家专业杀虫的老牌公司,百年间不断生产与研究,与各种虫子作斗争,杀虫技术得到广大消费者的信赖。如今,KINCHO金鸟不仅仅在杀虫防虫的领域取得了一定的成就,对于家居生活这一块也颇有研究。

KINCHO金鸟TWINKLE厨房用醋酸除菌防臭洗涤剂拥有强大清洁能力的秘密就是采用了两种酸的力量,醋成分中的“醋酸”,能将厨房产生的水垢、皂垢等污垢分解成易溶于水的成分,提高水垢洗涤力的富马酸成分使洗涤力得到进一步提升。厨房的洗碗池(水槽)、水龙头、排水口、排水口过滤网、垃圾角、洗漱台的洗面池及水龙头都能进行使用。
让我们看看TWINKLE厨房用醋酸除菌防臭洗涤剂强大的洗涤效果。

在人工水垢的洗涤试验中,与老款产品相比,新产品将水垢洗得更干净。
新款TWINKLE厨房用醋酸除菌防臭洗涤剂不仅洗涤能力强大,除菌的效果也是有目共睹,经过实验证明,它1分钟能去除99%以上的普通细菌(※不能去除所有的细菌)。
同时TWINKLE厨房用醋酸除菌防臭洗涤剂采用特殊抗菌剂配方,可抑制排水口内的细菌繁殖,起到防止恶臭的作用。通过KINCHO金鸟公司的调查发现,向排水口内喷射5下,对次日早上排水口的臭味进行评价,其结果显示,76%的人确认了防臭效果。虽然添加了醋酸成分,但TWINKLE厨房用醋酸除菌防臭洗涤剂的醋酸气味降低,味道更佳清新柔和。
KINCHO金鸟除了有清洁厨房的产品,同系列还有 TWINKLE浴室用醋酸除菌节水洗涤剂和TWINKLE厕所用洗涤剂2way喷射,家里任何需要去除污垢的地方KINCHO金鸟都能帮您解决。有了KINCHO金鸟,还您一个洁净舒适的环境。
丽人网:www.mcladychina.com
春天已经悄然靠近啦~~那么换季... <详情>
【2019年5月15日,澳洲】近日,A... <详情>
Perlier倍俪娅,坐落于阿尔卑斯... <详情>